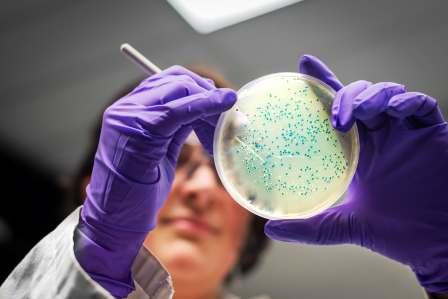

আজ বিশ্ব বিরল ব্যাধি দিবস। বিশ্বে প্রায় ৫,০০০ থেকে ৮,০০০ ধরনের বিরল ব্যাধির অস্তিত্ব রয়েছে। প্রায় ৩৫ কোটি বিশ্ববাসী বিরল ব্যাধিতে আক্রান্ত।

৮০% ক্ষেত্রে দায়ী জিনগত ত্রুটি
প্রীতিময় রায়বর্মন
অসুখ–বিসুখ নিয়ে মাঝেমধ্যে একটি বাক্য কানে আসে— ‘এ অসুখ তো লাখে একজনের হয়’ বা ‘এ অসুখ তো হাজারে একজনের হয়’। সাধারণত বিরল কোনও অসুখের ক্ষেত্রে এই কথাগুলো শোনা যায়। এমন কিছু অসুখ রয়েছে যেগুলোতে হাজারে একজন আক্রান্ত হন। সেই সব অসুখকেই বলা হয় ‘রেয়ার ডিজিজ’ বা ‘বিরল ব্যাধি’। যেমন প্রোজেরিয়া, এপিডার্মো ডিসপ্লেশিয়া ভেরুকোফরমিস, ক্লেপটোম্যানিয়া, পিকা সিনড্রোম ইত্যাদি।

নামে বিরল ব্যাধি হলেও, বিরল ব্যাধির সংখ্যা কিন্তু কম নয়। সারা বিশ্বে প্রায় ৫,০০০ থেকে ৮,০০০ ধরনের বিরল ব্যাধির অস্তিত্ব রয়েছে। প্রায় ৩৫ কোটি বিশ্ববাসী বিরল ব্যাধিতে আক্রান্ত। যা বিশ্বের মোট জনসংখ্যার প্রায় ৪.৫%। আর এই বিরল ব্যাধির ৮০%–এর জন্যই দায়ী জিনগত ত্রুটি।
বিরল ব্যাধির ব্যাখ্যায় ইউরোপীয় ইউনিয়ন বলছে, যে সব রোগে আক্রান্তের সংখ্যা প্রতি ২,০০০–এ ১ জন, সেই সব রোগই হল বিরল ব্যাধি। বিভিন্ন দেশে বিরল ব্যাধির ব্যাখ্যা বিভিন্ন রকম। যেমন আমেরিকায় প্রতি ১,৫০০ জনে ১ জন, আবার জাপানে প্রতি ২,৫০০ জনে ১ জন যে অসুখে আক্রান্ত হন, সেটাই বিরল ব্যাধি।

ইউরোপিয়ান ইউনিয়ন ফর রেয়ার ডিজিজ–এর উদ্যোগে ২০০৮ সাল থেকে ফেব্রুয়ারি মাসের শেষ দিনটি (২৮ তারিখ, লিপ ইয়ার হলে ২৯ তারিখ) ‘বিরল ব্যাধি’ দিবস হিসেবে পালিত হয়ে আসছে। বিরল অসুখ সম্পর্কে সচেতনতা বাড়ানো, রোগের আধুনিক চিকিৎসা এবং আক্রান্ত ব্যক্তি ও তার পরিবারের পাশে থাকাই দিনটির প্রধান উদ্দেশ্য।
সব ছবি: আন্তর্জাল
Leave a Reply
Your email address will not be published. Required fields are marked *



Comments